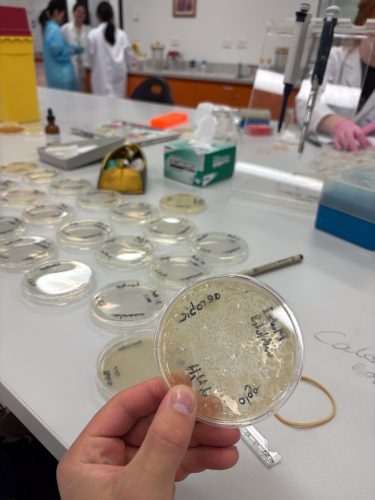

Hi! I’m Jamie, a 3rd year Marine Biology student, and I recently spent a semester studying at the University of New South Wales (UNSW), in Sydney. Â
Â
The first few weeks: In terms of accommodation, on campus options through the university were only offered for year abroad students, leaving me with the task of finding my own accommodation. I used two websites: flatmatefinders.com.au, and Flatmates.com.au. and started looking at options a month or so before arriving in the country. Once I landed, I stayed in a hostel in Coogee for a week and carried out house viewings.  After finding a suitable place to live, I quickly moved in and got settled into uni life! My house was a 10-minute walk from campus which was very helpful both in terms of saving money on public transport and for ease of getting to lectures/to the library to study, so would definitely recommend staying close to uni! I attended the international orientation talk/barbeque which was helpful in giving an overview of what the experience could look like. It also was a chance to meet people, although I found that just speaking to people during class is the best way to make friends. Its important to note that UNSW is split into three terms (trimesters), with the first terms being a 4-week ‘intensive’. I chose ‘the marine environment’ which was a very relaxed course, so allowed lots of sightseeing during these first weeks, but was not very helpful for making friends. So just bear this in mind if you are to take this module. In hindsight, joining some more societies could have helped me to connect with more students at the start. However if you are thinking of going to UNSW then dont worry, however, because once the second term started, there were many opportunities to make friends through group work etc. Â
Â
Once settled: After getting my bearings, it was time to explore! I usually chose to venture into the city via the light rail or bus, both of which ran frequently and were well-connected. Here are some of my favourite things to do in and around Sydney: Go up the Westfield Tower, walk over the Harbour Bridge, visit the Opera house and take the ferry to Manly. I also soon found out that residents of Sydney are known for being early risers, which I quickly adopted and ended up finding myself on many sunrise swims throughout the 4 months. As well as sunrises, I saw some great sunsets with some of my favourite spots being: Dudley Page Reserve, the botanical gardens, Parliament Hill and Milk beach.

Â
Nature: Whilst this may not be everyone’s cup of tea, whilst abroad I tried my best to experience as much of the local nature as possible, of which Australia has a lot to offer! Nature-based activities ranged from simply going for a walk in Centennial Park or the Botanic Gardens to hiking 20km in the Blue Mountains, snorkelling with sharks in Cabbage Tree Bay and going whale watching (seasonal between May-November). For a more condensed and logistically easier wildlife expereince I would recommend getting the ferry to Taronga Zoo where you can see an incredible range of animals from tigers to rare birds. The one nature based expereince that topped all of these however, was visiting the Daintree Rainforest. I stayed pretty off-grid in huts deep in the jungle at a place called Crocodylus and it was incredible! Whilst getting there and getting around without a car was quite difficult, I managed to make it work and was probably the most immersed in nature I have ever felt! So a must for anyone looking for this kind of experience!

Â
Travelling: Whilst Sydney itself is great, Australia has much more to offer and i would 100% recommend travelling around if you have the time/money! As well as going up to Cairns and the Daintree rainforest, I also managed to visit my friend in Melbourne for a few days both during term term. For a longer trip however I would recommend waiting until after exams finish in early December and utilising this time at the end of the exchange to travel further afield/for longer. During this time I flew to Brisbane where some friends and I hired a camper and hired a camper and drove it all the way back down to Sydney! This trip was incredible and I’d very much recommend anyone do the same…the freedom of having a van was amazing, and our days were filled with surfing, sightseeing, hiking and then some amazing nights out. Whilst all different, each trip was a great experience and helped me to experience Australia more as a whole rather than just the bubble of Sydney, which I think is key especially when visiting a new place!

Â
Final thoughts: I should mention that the whole trip was of course, very expensive, so if you are considering also going to Sydney, then make sure you have sufficient savings or can work whilst you are out there. However If you are fortunate enough to afford it then go for it, you will not regret it!  I have added a few photos below to give an insight into some of the amazing places I visited and experiences I had…

